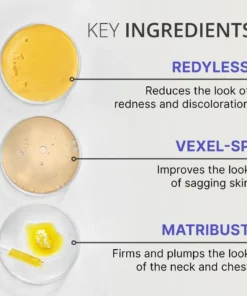
PureLift - Anti Wrinkle Neck Cream

Package Includes: 1 x PureLift – Anti Wrinkle Neck Cream
Welcome to WOWELO You’ve just found the greatest online store for most of your needs. Browse our website and stay tuned to our social media for great discount opportunities. We are constantly stocking products to make your life that much better. WOWELO is 4 years old online shopping company serving people in various industry products. WOWELO is completely
independent company so our loyalty only belongs to our clients, we do our best to serve fully our customers.We believe that trust between us is very important. Feel free to contact the WOWELO at any time! We love you and thanks for being part of the WOWELO.
__________________________________________________________________________________
OUR GUARANTEE
We truly believe we make some of the most innovative products in the world, and we want to make sure we back that up with a risk-free ironclad 45 day guarantee.
If you don’t have a positive experience for ANY reason, we will do WHATEVER it takes to make sure you are 100% satisfied with your purchase.
Buying items online can be a daunting task, so we want you to realize that there is absolute ZERO risk in buying something and trying it out. If you don’t like it, no hard feelings we’ll make it right.
We have 24/7/365 Ticket and Email Support. Please contact us if you need assistance.
Remember: Shipping usually takes 2-3 weeks – read our shipping for more details!
100% MONEY BACK GUARANTEE
PureLift – Anti Wrinkle Neck Cream

Reviews
There are no reviews yet.